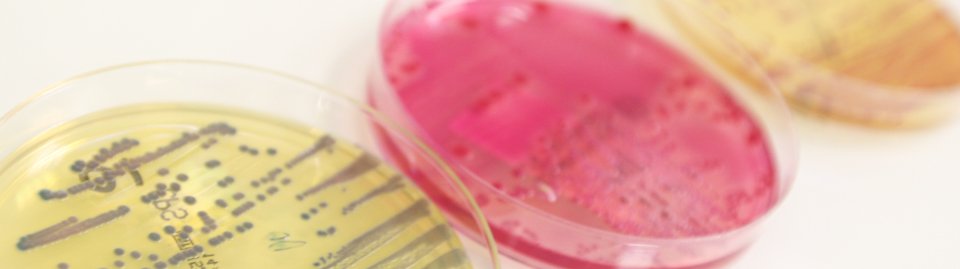
image à droite

Spermiologie
-
Recueil de sperme

Spermogramme - Spermocytogramme
 Le spermogramme permet l’analyse quantitative et qualitative des spermatozoïdes,
et évalue également en partie la qualité des sécrétions des glandes associées.
La production de spermatozoïdes par les testicules se met en place à la puberté.
C’est ensuite un phénomène continu, qui peut présenter des fluctuations importantes
pour un même individu, même sans problème de santé. En cas de résultats pathologiques,
il peut être souhaitable de répéter l’examen, notamment en cas d’épisode infectieux survenu dans les 3 mois précédents.
Le spermocytogramme, indissociable du spermogramme, évalue la morphologie des spermatozoïdes.
Le spermogramme permet l’analyse quantitative et qualitative des spermatozoïdes,
et évalue également en partie la qualité des sécrétions des glandes associées.
La production de spermatozoïdes par les testicules se met en place à la puberté.
C’est ensuite un phénomène continu, qui peut présenter des fluctuations importantes
pour un même individu, même sans problème de santé. En cas de résultats pathologiques,
il peut être souhaitable de répéter l’examen, notamment en cas d’épisode infectieux survenu dans les 3 mois précédents.
Le spermocytogramme, indissociable du spermogramme, évalue la morphologie des spermatozoïdes.Spermoculture
La spermoculture est la mise en culture de l’éjaculat à la recherche de germes pathogènes (bactéries, levures, chlamydia,mycoplasmes…). Les infections asymptomatiques de l’appareil génital masculin peuvent être à l’origine d’infertilité masculine.
La spermoculture est la mise en culture de l’éjaculat à la recherche de germes pathogènes (bactéries, levures, chlamydia,mycoplasmes…). Les infections asymptomatiques de l’appareil génital masculin peuvent être à l’origine d’infertilité masculine.
Test de migration de survie
 Le test de survie permet de sélectionner les spermatozoïdes les plus mobiles et a priori
les plus fécondants. C’est une mise en situation de l’éjaculât tel qu’il serait traité lors
d’une préparation en vue d’insémination.Ce test permet d’évaluer quelle technique d’Aide Médicale
à la Procréation est la plus appropriée pour le couple, selon la quantité de spermatozoïdes mobiles
disponibles à l’issue du test et leur survie à 24h. Cet examen est soumis à une demande d’entente préalable.
Le test de survie permet de sélectionner les spermatozoïdes les plus mobiles et a priori
les plus fécondants. C’est une mise en situation de l’éjaculât tel qu’il serait traité lors
d’une préparation en vue d’insémination.Ce test permet d’évaluer quelle technique d’Aide Médicale
à la Procréation est la plus appropriée pour le couple, selon la quantité de spermatozoïdes mobiles
disponibles à l’issue du test et leur survie à 24h. Cet examen est soumis à une demande d’entente préalable.Test de dépistage des anticorps anti-spermatozoïdes – Recherche directe = Mar Test
 La présence d’anticorps fixés sur les spermatozoïdes peut être responsable d’une altération de la mobilité et/ou de l’agglutination des spermatozoïdes entre eux, réduisant de fait leur pouvoir fécondant.
Le Mar Test permet le dépistage de ces anticorps. En cas de positivité, la présence d’anticorps doit être vérifiée par le test de confirmation (recherche d’ACAS).
Cet examen est soumis à une demande d’entente préalable.
Lors de la mise en évidence d’agglutinats dans le spermogramme, un Mar Test est automatiquement réalisé et la demande d’entente préalable est rédigée par le laboratoire.
La présence d’anticorps fixés sur les spermatozoïdes peut être responsable d’une altération de la mobilité et/ou de l’agglutination des spermatozoïdes entre eux, réduisant de fait leur pouvoir fécondant.
Le Mar Test permet le dépistage de ces anticorps. En cas de positivité, la présence d’anticorps doit être vérifiée par le test de confirmation (recherche d’ACAS).
Cet examen est soumis à une demande d’entente préalable.
Lors de la mise en évidence d’agglutinats dans le spermogramme, un Mar Test est automatiquement réalisé et la demande d’entente préalable est rédigée par le laboratoire.Anticorps anti-spermatozoïdes – Recherche indirecte = ACAS
Ce test de confirmation n’est réalisé et remboursé que si le test de dépistage des anticorps anti-spermatozoïdes est positif. Au cours de ce test, une caractérisation du type d’anticorps et une quantification sont réalisées, à la fois dans le sperme et dans le sang. Cet examen est soumis à une demande d’entente préalable.
Test de fragmentation de l’ADN
 L’ADN du spermatozoïde,
support du génome d’un individu est une longue molécule fragile et fortement compactée. La forme stable de la chromatine du spermatozoïde
(ADN + protéines) est indispensable au processus normal de la fécondation et au développement embryonnaire.
Pour des raisons diverses, il arrive que les brins d’ADN se dissocient d’une manière excessive : il y a alors fragmentation de L’ADN.
Habituellement, l’ovocyte contribue à réparer ces coupures anormales après fécondation, sous réserve qu’elles se trouvent dans une proportion
raisonnable. Au-delà d’un certain seuil, les mécanismes de réparations sont alors dépassés et le développement embryonnaire ne peut pas se poursuivre.
On retrouve ce phénomène de fragmentation dans un certain nombre de cas : infertilités inexpliquées, fausses-couches à répétition, échecs
d’implantation…. Cet examen n’est pas pris en charge par les caisses d’assurance maladie. Pour le tarif, voir avec le laboratoire.
L’ADN du spermatozoïde,
support du génome d’un individu est une longue molécule fragile et fortement compactée. La forme stable de la chromatine du spermatozoïde
(ADN + protéines) est indispensable au processus normal de la fécondation et au développement embryonnaire.
Pour des raisons diverses, il arrive que les brins d’ADN se dissocient d’une manière excessive : il y a alors fragmentation de L’ADN.
Habituellement, l’ovocyte contribue à réparer ces coupures anormales après fécondation, sous réserve qu’elles se trouvent dans une proportion
raisonnable. Au-delà d’un certain seuil, les mécanismes de réparations sont alors dépassés et le développement embryonnaire ne peut pas se poursuivre.
On retrouve ce phénomène de fragmentation dans un certain nombre de cas : infertilités inexpliquées, fausses-couches à répétition, échecs
d’implantation…. Cet examen n’est pas pris en charge par les caisses d’assurance maladie. Pour le tarif, voir avec le laboratoire.
Biochimie séminale
 Le sperme est constitué,
d’une part, d’une suspension concentrée de spermatozoïdes baignant dans un liquide épididymaire et, d’autre part, de différentes sécrétions complexes
provenant des organes annexes : prostate, vésicules séminales. Le dosage des marqueurs biochimiques (Citrate, Alpha Glucosidase et Fructose) peut apporter des renseignements sur l’origine d’une azoospermie (absence de spermatozoïdes dans l’éjaculât).
Cet examen est soumis à une demande d’entente préalable.
Le sperme est constitué,
d’une part, d’une suspension concentrée de spermatozoïdes baignant dans un liquide épididymaire et, d’autre part, de différentes sécrétions complexes
provenant des organes annexes : prostate, vésicules séminales. Le dosage des marqueurs biochimiques (Citrate, Alpha Glucosidase et Fructose) peut apporter des renseignements sur l’origine d’une azoospermie (absence de spermatozoïdes dans l’éjaculât).
Cet examen est soumis à une demande d’entente préalable. Recherche d’éjaculation rétrograde
Lors d’une éjaculation rétrograde, le sperme est expulsé vers la vessie en partie ou en totalité. On suspecte ce phénomène lorsque le volume d’éjaculât est très faible ou inexistant alors que la sensation orgasmique est conservée.
Un spermogramme, un test de migration de survie ou une préparation pour insémination peuvent être réalisé à partir des spermatozoïdes récupérés dans l’urine alcaline recueillie après masturbation. Il est nécessaire de suivre un protocole rigoureux d’alcalinisation des urines quelques jours avant l’examen.
Cet examen est soumis à une demande d’entente préalable.







